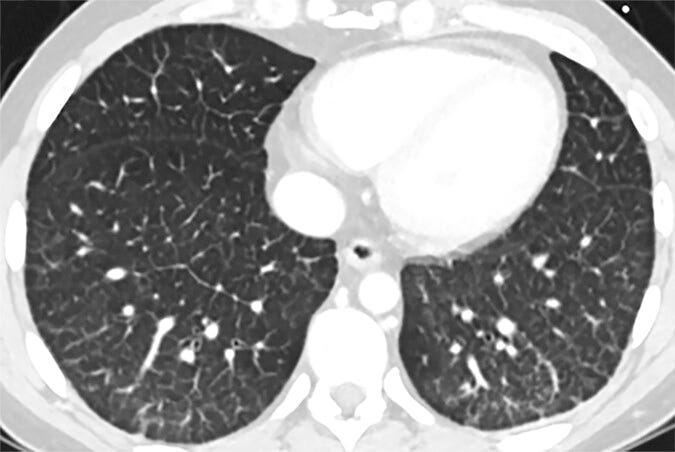

Breathing Fire
When Heat Turns Nanoparticles Into Lung-Destroying Weapons
Something clicked for me reading Ricky’s Substack article “30 Clues That Let Us Know COVID Was A Planned Operation | Part VIII: EVALI” and I can’t stop thinking about it. He points out that the lung injury labeled as “COVID lung” looked almost identical to what doctors were already seeing in heavy vape users for years. Ground glass imaging. Scarred bronchioles. Oxygen exchange that never quite recovers. The clinical picture of bronchiolitis obliterans, more commonly called popcorn lung. The common factor is not some mythical viral enemy. The common factor is heat… plus nanoparticles.
Think about how vaping works. A chemical cocktail loaded with nanoparticles gets heated to the point of aerosolization and then inhaled deep into the lung. That heat does not just turn a liquid into vapor. It transforms the nanoparticles themselves. They fragment. They shrink. They become ultrafine. They become more reactive. Because they are smaller, they slip past your upper airway defenses and lodge in alveoli only microns thick. Once there, they do not sit politely. Macrophages swarm. Cytokines surge. Oxidative stress spirals. Tissue swells. Gas exchange falters. The lungs go on full alert. The inflammation does not go away easily. Poof. You have Long Popcorn Lung.
Then expand this beyond vapes. Heated hair products, for instance. Many hair products contain nanoparticle ingredients. When you run a heating wand, curling iron, hair dryer, or straightener through your hair, you are not just styling. You are creating heated ultrafine nanoparticles that go airborne, reach your alveoli, and trigger the same kind of inflammatory response. Some researchers (me) have started calling this “hair product lung”. The mechanism is identical. Heat alters the particles. The particles go deep. Your lung tissue fights back. Beauty really can kill.
As previously mentioned a few days ago in one of my Substacks, layer in wildfire smoke from around late 2019 to 2023 (when “COVID” was at its prime). Entire regions were engulfed in dense smoke from unprecedented fires.
The Nanoparticle Nightmare
Nanoparticles have invaded every corner of modern life. They are in vaccines, and in pretty much every other pharmaceutical you can imagine, food additives, cosmetics, cleaning products, paints, coatings, electronics, weather engineering, and water treatment systems. People inhale them, ingest them, absorb them through the skin, and in millions of cases…
Those fires do not just generate big chunks of ash. They produce massive quantities of ultrafine particulate matter (AKA nanoparticles) from massive “weather modification” programs. And legally organizations or companies involved in weather modification projects don’t have to disclose all the nanoparticles they may be spraying in the skies. Combustion chemistry is messy, chaotic, and reactive. High heat breaks down materials. It fragments them and produces particles with enormous surface area relative to size. These particles can trigger oxidative stress and chronic inflammation once inhaled. People inhaled this day after day, week after week, month after month. Lungs that were already sensitive became saturated with reactive, heat-transformed nanoparticles.
Even after wildfire smoke has traveled miles, the particles you breathe in can be much smaller and nastier than the original material. Extreme heat from the fire fragments larger particles into ultrafine pieces and changes their chemistry, making them brittle and more reactive. These tiny particles slip deep into your lungs, evade your defenses, and trigger inflammation, oxidative stress, and immune reactions far more aggressively than particles that never experienced fire. The particles don’t need to be physically hot when they reach you; the damage comes from how heat altered their structure and surface before they even left the fire.
Nanoparticles are defs not inert. Many have conductive or dielectric properties. When exposed to strong electromagnetic fields, think 5G towers, Wi-Fi, or intense cellular energy, they can absorb that energy and convert it into heat at a microscopic scale. Tiny energy input produces localized heating deep in tissue. Thermal stress inside your body is real. Protein structures strain. Cell membranes destabilize. Signaling pathways flare. “Immune” (detox) cells get triggered. Inflammation intensifies.
Here is what happens if you connect the dots. Nanoparticles are introduced into the body (especially the lungs) from vaping , “wildfire” smoke, or heated hair products. Heat from fire, aerosolization, or EMF energy alters these particles. They become smaller, more reactive, and more penetrative. Once they reach delicate lung tissue, they trigger “immune” (detox) responses, oxidative stress, and inflammation. But look away. It’s going to make communication SOOOOO much better. Mmmmk?
Radiologists call the result “COVID lung” or “popcorn lung”. The mechanism has been staring us in the face for years. It’s. So. Simple. Call it what you want. Popcorn lung. Hair product lung. COVID lung. Nanoparticle lung. Not a virus making my long not work lung.
Heat plus reactive particles equals deep, aggressive major inflammation in the lungs. Energy absorption amplifies the storm. We have been living exposed to these conditions for years without even thinking about it. The focus remains on a single non-existent villain while the real mechanism of injury is ignored. Ultra fine nanoparticles transformed by heat and energized by our modern environment can trigger the same destructive lung responses in millions of people. The lungs don’t lie. The mechanism is sitting there like a middle finger in microscopic form.

Don't forget to include EMFs from wifi, smart meters, cell towers/5G, solar panels, high Tesla fields (Tesla is a measurement of high EMF fields, and apparently 4 T or 4 Tesla is safe but 100T which is average field in most EV cars are not.
See saveusnow substack podcasts by Mark Steele.
Amen, amen, but now I have to worry about my grandchildren and heated hair products in addition to everything else. The dots we’ve been following are nano. Good eye!